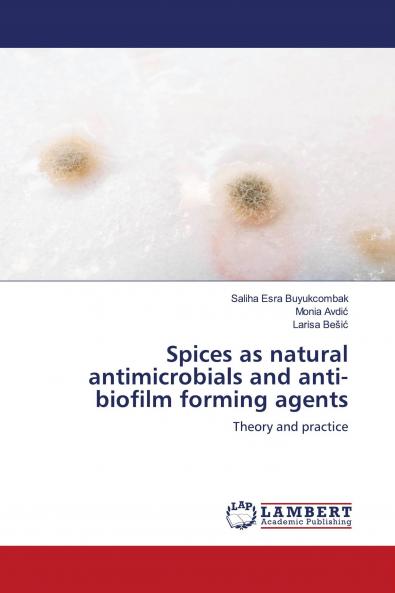
Spices as natural antimicrobials and anti-biofilm forming agents

English
Paperback
₹4195
(All inclusive*)
Delivery Options
Please enter pincode to check delivery time.
*COD & Shipping Charges may apply on certain items.
Review final details at checkout.
Looking to place a bulk order? SUBMIT DETAILS
About The Book
Description
Author
In addition to their role as flavor enhancer spices are known antimicrobials found naturally in food products. As various studies have demonstrated that spices have shown promise in serving as anti-biofilm agents the focus of this book is to provide an insight in what is known so far regarding the antimicrobial and anti-biofilm forming properties of three of the most commonly consummated spices – namely curcuma cinnamon and ginger. In addition we demonstrate in detail how antimicrobial and anti-biofilm forming properties are tested in a common laboratory setting and how results of such assays are interpreted. Therefore besides reviewing data published on the benefits of spices on human health this book provides a foundation for all of those who wish to conduct similar experimental assays.
Delivery Options
Please enter pincode to check delivery time.
*COD & Shipping Charges may apply on certain items.
Review final details at checkout.
Details
ISBN 13
9786200295682
Publication Date
-05-10-2020
Pages
-72
Weight
-111 grams
Dimensions
-150x220x4.3 mm